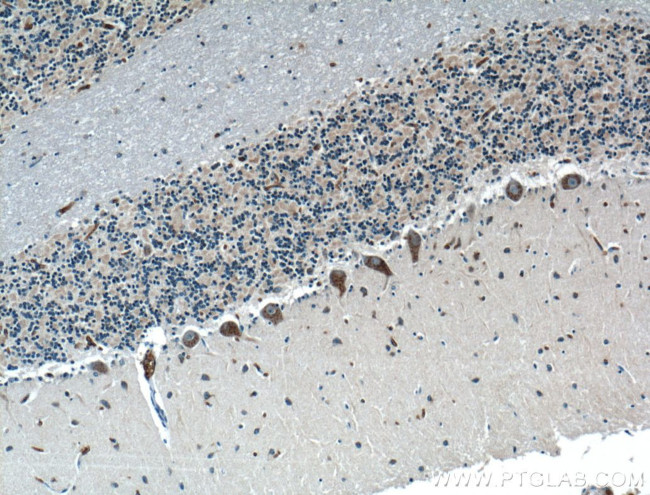
LRP2BP Antibody in Immunohistochemistry (Paraffin) (IHC (P))

Search
Proteintech
LRP2BP Polyclonal Antibody
{{$productOrderCtrl.translations['antibody.pdp.commerceCard.promotion.promotions']}}
{{$productOrderCtrl.translations['antibody.pdp.commerceCard.promotion.viewpromo']}}
{{$productOrderCtrl.translations['antibody.pdp.commerceCard.promotion.promocode']}}: {{promo.promoCode}} {{promo.promoTitle}} {{promo.promoDescription}}. {{$productOrderCtrl.translations['antibody.pdp.commerceCard.promotion.learnmore']}}
产品信息
25783-1-AP
种属反应
宿主/亚型
分类
类型
抗原
偶联物
形式
浓度
规格
纯化类型
保存液
内含物
保存条件
运输条件
产品详细信息
Immunogen sequence: DYTHANLVD KALQLLKERI LKGDTLAYFL RGQLYFEEGW YEEALEQFEE IKEKDHQATY QLGVMYYDGL GTTLDAEKGV DYMKKILDSP CPKARHLKFA AAYNLGRAYY EGKGVKRSNE EAERLWLIAA DNGNPKASVK AQSMLGLYYS TKEPKELEKA FYWHSEACGN GNLESQGALG LMYLYGQGIR QDTEAALQCL REAAERGNVY AQGNLVEYYY KMKFFTKCVA FSKRIADYDE VHDIPMIAQV TDCLPEFIGR GMAMASFYHA RCLQLGLGIT RDETTAKHYY SKACRLNPAL ADELHSLLIR QRI (36-347 aa encoded by BC152444)
靶标信息
May act as an adapter that regulates LRP2 function.
仅用于科研。不用于诊断过程。未经明确授权不得转售。
篇参考文献 (0)
生物信息学
蛋白别名: low density lipoprotein receptor-related protein 2 binding protein; LRP2-binding protein; Megalin-binding protein; MegBP; unnamed protein product
基因别名: KIAA1325; LRP2BP; RGD1305896
UniProt ID: (Human) Q9P2M1, (Rat) Q569C2
Entrez Gene ID: (Human) 55805, (Rat) 290753